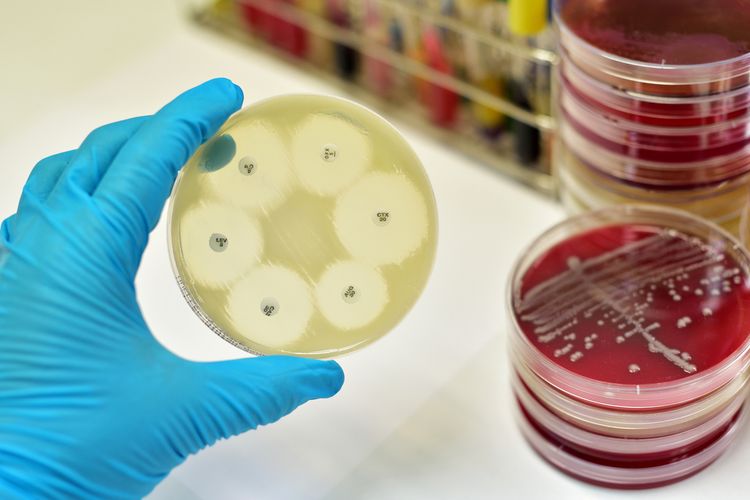

Pola Kepekaan Antimikroba dan Pola Distribusi Gene blaOXA-23 pada Acinetobacter baumannii Isolate Klinis di Rumah Sakit Rujukan Tersier di Indonesia
Acinetobacter baumannii adalah bakteri Gram-negatif, oksidase-negatif, non-rewel, dan sangat aerobik yang telah menjadi masalah kesehatan yang signifikan secara global. Ini dapat mengakumulasi berbagai mekanisme resistensi










